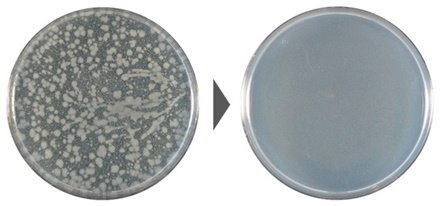
大腸菌の除菌効果試験結果の写真
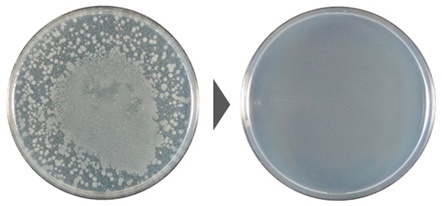
サルモネラ菌の除菌効果試験結果の写真

微酸性電解水について
当社の微酸性電解水(除菌に・この水)は、水に希塩酸を添加した水溶液を特殊な製法で電気分解することによってpH5~6.5、有効塩素濃度10~50ppmに調整した除菌・消臭効果の高い水です。
微酸性電解水の除菌作用
微酸性電解水の除菌力の主体は、水を電気分解することによって発生したHOCl(次亜塩素酸)という成分です。
このHOClは、細菌の細胞壁に侵入し、タンパク質やDNAを破壊する作用があります。細菌はひとつの細胞で成り立っているので、細胞壁に侵入されるだけで損傷され、タンパク質の破壊によってエネルギーを得られなくなり、DNAが破壊されると子孫を残すことができなくなります。

除菌といえば、エタノール等の成分が入ったアルコール系の除菌剤が一般的に多く使われています。しかし、アルコールは菌のタンパク質を一時的に変性させることができますがDNAまでは破壊できません。そのため一時的には除菌できても時間が経てば菌が復活し増殖することになります。また、アルコール系はニオイもきつく手荒れの原因にもなります。
微酸性電解水によって一度破壊された菌のDNAは復活することはなく、外部から新たな菌の付着がない限り、増殖することはありません。また、ニオイも少なく(わずかに塩素臭がありますが)、微酸性なので肌にも優しい水です。
微酸性が良い理由
では、どうして微酸性が良いのでしょうか?
人の肌に近いpHだから肌に優しいというだけでなく深い理由があります。
それは除菌力の主体であるHOClがpH5~6.5の微酸性域において最も安定して存在できるからです。

HOClはpHが低くなるとCl2(塩素ガス)になります。同じ電解水である強酸性電解水も除菌効果の高い水ですが、Cl2が空気中にどんどん放出されるため塩素臭が強く、数日で除菌効果がなくなります。したがって、電解水生成機を導入し生成直後の水を使用する必要があります。また、強い酸性なので金属を腐食させる原因になります。
逆にpHが高くなると除菌効果の低いOCl–(次亜塩素酸イオン)に変わってしまいます。一般的に殺菌消毒に良く使われる次亜塩素酸ナトリウム溶液は、pHが高いのでHOClの存在が低くOCl–が主成分です。したがって、高濃度で使用しなければ効果がありませんが、十分なすすぎが必要、塩素臭が強い、有害物質(クロロホルム)を発生させるなど、取扱いには注意が必要です。
その点、微酸性電解水pH5~6.5の範囲ではHOClの存在が高く、安定した除菌効果を長時間維持することができます。また、塩素濃度が低くCl2も発生しないので塩素臭は少なく、有害物質の発生もありません。臭いの元である菌を効率的に除去できるので高い消臭効果があり、水道水と同じ感覚で色々な物や場所、食品にも安全に使用することができる水です。
他の消毒剤と微酸性電解水のちがい
微酸性電解水は、アルコール系や次亜塩素酸ナトリウム(次亜ソー)系の除菌・消毒剤よりも幅広い菌やウィルスに効果があります。

上の図では、下に行くほど耐性が強い細菌・ウィルスです。
一般的なアルコール系消毒剤は、細菌のタンパク質を変性させることによって消毒しますが、ウィルスや芽胞菌を破壊するほどの力はありません。
また、キッチンハ○ターや漂白剤などの次亜ソー系消毒剤は、細胞壁に侵入する力が弱く、芽胞菌のような耐性の強い菌には効果がありません。
微酸性電解水はHOClの力によって、ほとんど全ての細菌や芽胞菌を破壊し、ウィルスを不活化させる力を持った水です。
殺菌効果試験結果
一般財団法人 日本食品分析センターにて、大腸菌・サルモネラ菌・黄色ブドウ球菌に対する微酸性電解水の殺菌効果試験を実施しました。(2014.6.26)

大腸菌
人間や動物の糞便の中に多く存在し、トイレや下着・ペット用品等に付いていることが多い菌です。通常は人体への影響は少ないのですが、中にはO-157のように強い病原性を持った種類もあり、恐ろしい食中毒を引き起こします。

サルモネラ菌
生の肉や魚の中に多く存在するので、まな板や包丁に残りやすい菌です。また賞味期限が過ぎたものや加熱不足のものを食して人体に入る可能性もあります。病原性があり、激しい腹痛と下痢の症状が現れます。

黄色ブドウ球菌
人間や動物の消化器官や皮膚表面にも存在する耐性の強い菌です。傷口から侵入して皮膚を化膿させたり、一定以上の量が人体に入ると嘔吐や腹痛の症状が現れます。ドアノブや手すりなど、人がよく触るものに付いていることも多い菌です。
上記3種類の菌の試験結果から、当社の微酸性電解水(除菌に・この水)は15秒で菌を99.9%除去できる水であることを確認しました。
